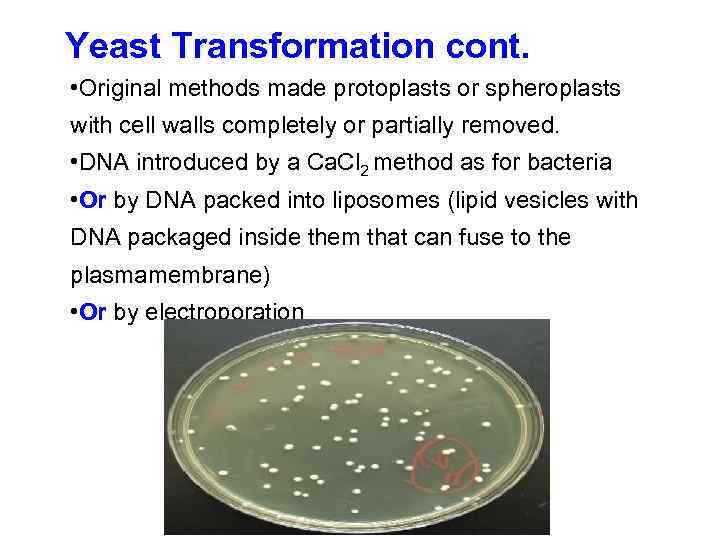
Yeast Transformation cont. • Original methods made protoplasts or spheroplasts with cell walls completely

Lecture_7_Gene_amp_amp_protein_technologies.ppt
- Количество слайдов: 38
 Экспрессия чужеродных генов и системы трансформации
Экспрессия чужеродных генов и системы трансформации
 Что такое трансформация? • Это введение ДНК неполовым путем в клетку реципиента, проводящее к наследуемому изменению генотипа • Основной метод биотехнологии растений и мощнейшая экспериментальная методика • Убирает барьеры по переноске генов • Развитие трансформации E. coli, а также разрезание и сшивание ДНК in vitro дало начало генетической революции в 70 -е годы • Не надо путать с генетической трансдукцией, представляющей собой частный случай пепеноса генов между хозяином и вирусом
Что такое трансформация? • Это введение ДНК неполовым путем в клетку реципиента, проводящее к наследуемому изменению генотипа • Основной метод биотехнологии растений и мощнейшая экспериментальная методика • Убирает барьеры по переноске генов • Развитие трансформации E. coli, а также разрезание и сшивание ДНК in vitro дало начало генетической революции в 70 -е годы • Не надо путать с генетической трансдукцией, представляющей собой частный случай пепеноса генов между хозяином и вирусом
 Трансформация происходит в природе Некоторые примеры: 1. Секвенирование геномов четко показало, что у бактерий существует горизонтальный перенос генов между разными видами при определенных селектинвых преимуществах (условиях отбора) 2. Формирование раковых клеток у животных под действием онкогенных вирусов, таких как SV 40 и аденовирусов. Часть вирусной ДНК интегрируется в ДНК хозяина и вызывает неконтролируемый рост клеток (в биологии рака существует свое более узкое определение трансформации) 3. У растений, такких как бананы, табак и кокос tobacco, малые ДНК-вирусы (баднавирусы и нановирусы) интегрируются в виде множественных копий в ДНК хозяина при стрессе (вызывая потерю стрессоустойчивости). Это является существенной помехой программ селекции бабанов.
Трансформация происходит в природе Некоторые примеры: 1. Секвенирование геномов четко показало, что у бактерий существует горизонтальный перенос генов между разными видами при определенных селектинвых преимуществах (условиях отбора) 2. Формирование раковых клеток у животных под действием онкогенных вирусов, таких как SV 40 и аденовирусов. Часть вирусной ДНК интегрируется в ДНК хозяина и вызывает неконтролируемый рост клеток (в биологии рака существует свое более узкое определение трансформации) 3. У растений, такких как бананы, табак и кокос tobacco, малые ДНК-вирусы (баднавирусы и нановирусы) интегрируются в виде множественных копий в ДНК хозяина при стрессе (вызывая потерю стрессоустойчивости). Это является существенной помехой программ селекции бабанов.
 Трансформация бактерий
Трансформация бактерий
 Важные требования к трансформации 1. Возможность ДНК экспессироваться в клетках хозяина (реципиента) 2. Клетки реципиента часто требуют специальной обработки для того, чтобы сделать их «компетентными» к трансформации 3. Система доставки ДНК 4. Системы селекции для распознавания и отбора трансформантов
Важные требования к трансформации 1. Возможность ДНК экспессироваться в клетках хозяина (реципиента) 2. Клетки реципиента часто требуют специальной обработки для того, чтобы сделать их «компетентными» к трансформации 3. Система доставки ДНК 4. Системы селекции для распознавания и отбора трансформантов
 Что такое экспрессия генов? Это совокупность реакций, вследствие которых биологическая информация гена становится доступной клетке (работа или активность гена)
Что такое экспрессия генов? Это совокупность реакций, вследствие которых биологическая информация гена становится доступной клетке (работа или активность гена)
 эукариоты прокариоты Экспрессия генов
эукариоты прокариоты Экспрессия генов
 РНК-процессинг у эукариот
РНК-процессинг у эукариот
 Конструирование генов для их экспрессии в других видах • Нужно знать экспрессируется ли ген (часто уже известно). • Если ген из того же или близкого таксона, то ожидается, что он будет экспрессироваться точно также как в организме-источнике (доноре). Например, ген из двудольных растений практически всегда будет нормально экспрессироваться в другом двудольном растении Гены разных энтерических бактерий будут работать в таких же бактериях без дополнительных модификаций Гены человека «работают» в мышах • Если кодирующая последовательность из другого царства, то очень вероятно, что она не будет фукнционировать. Такая последовательность потребует дополнительной добавки – последовательности совместимости, или промотера. • Таким образом. часто требуется создание нового гена – химерной последовательности или ХИМЕРЫ, которую можно создать in vitro (предыдущая лекция) • Все гены (химерные или немодифицированные) пропагируются (наращивается число их копий) при помощи трансформации на плазмидных векторах в бактериях или грибах.
Конструирование генов для их экспрессии в других видах • Нужно знать экспрессируется ли ген (часто уже известно). • Если ген из того же или близкого таксона, то ожидается, что он будет экспрессироваться точно также как в организме-источнике (доноре). Например, ген из двудольных растений практически всегда будет нормально экспрессироваться в другом двудольном растении Гены разных энтерических бактерий будут работать в таких же бактериях без дополнительных модификаций Гены человека «работают» в мышах • Если кодирующая последовательность из другого царства, то очень вероятно, что она не будет фукнционировать. Такая последовательность потребует дополнительной добавки – последовательности совместимости, или промотера. • Таким образом. часто требуется создание нового гена – химерной последовательности или ХИМЕРЫ, которую можно создать in vitro (предыдущая лекция) • Все гены (химерные или немодифицированные) пропагируются (наращивается число их копий) при помощи трансформации на плазмидных векторах в бактериях или грибах.
 Химера. Что это значит? Организм, орган или часть организма, содержащая две или более генетические составляющие. Получается в результате трансплантации органов, пересадок или генетической инженерии. Вещество, такое как антитела, созданное из белков различных видов. From Latin chimaera, from Greek khimaira, chimera, she-goat – она-коза – комбинаций двух зверей (чаще козы и льва)
Химера. Что это значит? Организм, орган или часть организма, содержащая две или более генетические составляющие. Получается в результате трансплантации органов, пересадок или генетической инженерии. Вещество, такое как антитела, созданное из белков различных видов. From Latin chimaera, from Greek khimaira, chimera, she-goat – она-коза – комбинаций двух зверей (чаще козы и льва)
 Пример генной кассеты (плазмидной конструкции высокой интенсивности) для трансформации растений Плазмидный вектор (p. UC 12) Ca. MV 35 S promoter Ca. MV polyadenylation sequence
Пример генной кассеты (плазмидной конструкции высокой интенсивности) для трансформации растений Плазмидный вектор (p. UC 12) Ca. MV 35 S promoter Ca. MV polyadenylation sequence
 Дрожжевая экспрессионная кассета GAL 1 • Включает сильный индуцибельный промотер GAL 1 (галактоза индуцирует экспрессию, в глюкоза ингибирует) • Доступна коммерчески (фирма - Invitrogen) • Содержит рекомбинационную систему Gateway • Дает высокий уровень экспрессии белка и возможность легкой очистки • Полиаденилатный сайт из CYC 1 -гена • Способна экспрессироваться в E. coli
Дрожжевая экспрессионная кассета GAL 1 • Включает сильный индуцибельный промотер GAL 1 (галактоза индуцирует экспрессию, в глюкоза ингибирует) • Доступна коммерчески (фирма - Invitrogen) • Содержит рекомбинационную систему Gateway • Дает высокий уровень экспрессии белка и возможность легкой очистки • Полиаденилатный сайт из CYC 1 -гена • Способна экспрессироваться в E. coli
 Гены селективных маркеров Трансформация происходит у малого числа клеток. Требуется создать преимущество для роста именно трансформированных клеток. Бактерии: Гены резистентности к антибиотикам Ген бета-лактамазы (уст-ть к ампицилину и тетрациклину) Дрожжи: Комплементация ауксотрофности Например URA 3 позволяет урацил-ауксотрофному мутанту расти на несодержащих урацил средах. Ауксотрофы - микроорганизмы, в противоположность прототрофам утратившие способность к самостоятельному синтезу какого–либо метаболита (аминокислоты, витамины и т. д. ) в результате мутации и потери способности к образованию соответствующих ферментов.
Гены селективных маркеров Трансформация происходит у малого числа клеток. Требуется создать преимущество для роста именно трансформированных клеток. Бактерии: Гены резистентности к антибиотикам Ген бета-лактамазы (уст-ть к ампицилину и тетрациклину) Дрожжи: Комплементация ауксотрофности Например URA 3 позволяет урацил-ауксотрофному мутанту расти на несодержащих урацил средах. Ауксотрофы - микроорганизмы, в противоположность прототрофам утратившие способность к самостоятельному синтезу какого–либо метаболита (аминокислоты, витамины и т. д. ) в результате мутации и потери способности к образованию соответствующих ферментов.
 Гены селективных маркеров Клетки животных: Resistance to antibiotics 1. G 418 resistance conferred by npt. II from Tn 5 of E. coli (kanamycin resistance gene), inactivates antibiotic by phosphorylation 2. methotrexate (DHFR; dihydrofolate reductase gene) this version has a mutation which means the enzyme cannot bind the drug Plant Cells • Resistance to antibiotics or herbicides 1. Kanamycin resistance conferred by npt. II (as above 2. Hygromycin resistance same aminoglycoside class as kanamycin but has a different resistance gene (aph IV) 3. Bialaphos/phosphinothricin/glufosinate ammonium is a herbicide (trade name Challenge, Basta, Herbiace) resistance conferred by gene from Streptomyces viridochromogenes (bar, pat). Bar = bialaphos resistance, pat= phosphinothricin acetyl transferase. Herbicide inactivated by acetylation http: //www. bdt. fat. org. br/binas/Library/cabi/harding. html
Гены селективных маркеров Клетки животных: Resistance to antibiotics 1. G 418 resistance conferred by npt. II from Tn 5 of E. coli (kanamycin resistance gene), inactivates antibiotic by phosphorylation 2. methotrexate (DHFR; dihydrofolate reductase gene) this version has a mutation which means the enzyme cannot bind the drug Plant Cells • Resistance to antibiotics or herbicides 1. Kanamycin resistance conferred by npt. II (as above 2. Hygromycin resistance same aminoglycoside class as kanamycin but has a different resistance gene (aph IV) 3. Bialaphos/phosphinothricin/glufosinate ammonium is a herbicide (trade name Challenge, Basta, Herbiace) resistance conferred by gene from Streptomyces viridochromogenes (bar, pat). Bar = bialaphos resistance, pat= phosphinothricin acetyl transferase. Herbicide inactivated by acetylation http: //www. bdt. fat. org. br/binas/Library/cabi/harding. html
 Selectable marker genes are always chimaeric genes for transformation of higher eukaryotes This site gives you some idea of the resources available for transformation http: //www. pgreen. ac. uk/a_pls_fr. htm
Selectable marker genes are always chimaeric genes for transformation of higher eukaryotes This site gives you some idea of the resources available for transformation http: //www. pgreen. ac. uk/a_pls_fr. htm
 Transformation of bacteria Some bacteria can be transformed simply by adding DNA to their culture • Classic experiments of O T Avery and colleagues proving DNA is hereditary material. • Pneumococcus non-pathogenic strain type IIR could be transformed to pathogenic large mucoid colonies by transforming with DNA from type IIIS strain (1 in 104 frequency) IIR IIIS
Transformation of bacteria Some bacteria can be transformed simply by adding DNA to their culture • Classic experiments of O T Avery and colleagues proving DNA is hereditary material. • Pneumococcus non-pathogenic strain type IIR could be transformed to pathogenic large mucoid colonies by transforming with DNA from type IIIS strain (1 in 104 frequency) IIR IIIS
 Transformation of bacteria continued Method 1: Chemical transformation. E. coli transformation • Grow culture to exponential phase, chill and centrifuge • Cells chilled and suspended in cold 50 m. M – 100 m. M Ca. Cl 2 at 1010/ml, mixed with plasmid DNA • Incubate on ice 30 minutes • Heat treat at 42ºC for 1 minute • Add medium and grow cells for 30 minutes to 1 hour to allow recovery • Spread aliquots on selective plates containing antibiotic • Frequency 104 – 105 per mg DNA • Now improved commercial competent cells 107 -108 per mg DNA (eg TOP 10 cells) • Salts may help coat DNA onto cells, heat shock is when DNA is taken up
Transformation of bacteria continued Method 1: Chemical transformation. E. coli transformation • Grow culture to exponential phase, chill and centrifuge • Cells chilled and suspended in cold 50 m. M – 100 m. M Ca. Cl 2 at 1010/ml, mixed with plasmid DNA • Incubate on ice 30 minutes • Heat treat at 42ºC for 1 minute • Add medium and grow cells for 30 minutes to 1 hour to allow recovery • Spread aliquots on selective plates containing antibiotic • Frequency 104 – 105 per mg DNA • Now improved commercial competent cells 107 -108 per mg DNA (eg TOP 10 cells) • Salts may help coat DNA onto cells, heat shock is when DNA is taken up
 Transformation of bacteria continued Method 2: Electroporation Typical protocol, eg. for Agrobacterium or Rhizobium Cultures grown to exponential phase, chilled and centrifuged • Cells suspended at ca. 1010/ml in chilled sterile distilled water • Above step repeated twice more to ensure no salt remains with the cells • Cells mixed with DNA on ice and transferred to chilled sterile electroporation cuvette • Voltage applied of 4000 – 8000 V/cm for several milliseconds in electroporation machine. • Cells added to medium, allowed to recover and plated as before • High frequencies of transformation, up to 109 per mg. • Optimal conditions for each species • Electroporation works by briefly depolarisiing membranes which then on re-polarisation take up DNA • Works with yeast, animal and plant cells
Transformation of bacteria continued Method 2: Electroporation Typical protocol, eg. for Agrobacterium or Rhizobium Cultures grown to exponential phase, chilled and centrifuged • Cells suspended at ca. 1010/ml in chilled sterile distilled water • Above step repeated twice more to ensure no salt remains with the cells • Cells mixed with DNA on ice and transferred to chilled sterile electroporation cuvette • Voltage applied of 4000 – 8000 V/cm for several milliseconds in electroporation machine. • Cells added to medium, allowed to recover and plated as before • High frequencies of transformation, up to 109 per mg. • Optimal conditions for each species • Electroporation works by briefly depolarisiing membranes which then on re-polarisation take up DNA • Works with yeast, animal and plant cells
 Electroporation machine Electroporation cuvettes
Electroporation machine Electroporation cuvettes
 Yeast Transformation Relevant genetics and molecular biology • Can efficiently produce eukaryotic proteins • S. cerevisiae standard tool for molecular tecnhiques (eg. Yeast 2 hybrid methods for establishing protein-protein interactions) • Stable transformants can be produced by homologus integration • Yeast shuttle vectors can be maintained as artificial chromosomes in yeast and as plasmids in E. coli • Insertion mutants can be produced • Preferred codon usage is known • Post translational modification occurs with proteolytic maturation • Can splice introns from animal genes
Yeast Transformation Relevant genetics and molecular biology • Can efficiently produce eukaryotic proteins • S. cerevisiae standard tool for molecular tecnhiques (eg. Yeast 2 hybrid methods for establishing protein-protein interactions) • Stable transformants can be produced by homologus integration • Yeast shuttle vectors can be maintained as artificial chromosomes in yeast and as plasmids in E. coli • Insertion mutants can be produced • Preferred codon usage is known • Post translational modification occurs with proteolytic maturation • Can splice introns from animal genes
 Yeast Transformation cont. • Transforming DNA should be linearised with a restriction enzyme. Opposite to transformation of bacteria • Most efficient method is the Lithium Acetate (Li. Ac)/PEG/ss-DNA method. Features are: 1. Cells grown to exponential, washed with water and suspended in water. Can be stored frozen 2. Polyethylene glycol (PEG) 3000 and Li+ allow DNA to be coated over cells 3. Single stranded fragmented DNA, made by boiling and freezing. acts as a carrier, protecting shuttle vector DNA from nucleases 4. Heat shock treatment, 42ºC for 40 minutes 5. Growth on selective media, colonies appear after 3 -4 days. http: //www. umanitoba. ca/faculties/medicine/biochem/gietz/Trafo. html
Yeast Transformation cont. • Transforming DNA should be linearised with a restriction enzyme. Opposite to transformation of bacteria • Most efficient method is the Lithium Acetate (Li. Ac)/PEG/ss-DNA method. Features are: 1. Cells grown to exponential, washed with water and suspended in water. Can be stored frozen 2. Polyethylene glycol (PEG) 3000 and Li+ allow DNA to be coated over cells 3. Single stranded fragmented DNA, made by boiling and freezing. acts as a carrier, protecting shuttle vector DNA from nucleases 4. Heat shock treatment, 42ºC for 40 minutes 5. Growth on selective media, colonies appear after 3 -4 days. http: //www. umanitoba. ca/faculties/medicine/biochem/gietz/Trafo. html
Yeast Transformation cont. • Original methods made protoplasts or spheroplasts with cell walls completely or partially removed. • DNA introduced by a Ca. Cl 2 method as for bacteria • Or by DNA packed into liposomes (lipid vesicles with DNA packaged inside them that can fuse to the plasmamembrane) • Or by electroporation
Yeast Transformation cont. • Original methods made protoplasts or spheroplasts with cell walls completely or partially removed. • DNA introduced by a Ca. Cl 2 method as for bacteria • Or by DNA packed into liposomes (lipid vesicles with DNA packaged inside them that can fuse to the plasmamembrane) • Or by electroporation
 Mammalian Cell Transformation • Calcium phosphate co-precipitation techniques • Both transient expression and stable transformation can be achieved at high frequencies of standard cells lines such He. La, CHO, NIH 3 T 3. 10 -50% of all cells • Procedure is often termed tranfection • Shuttle vectors used, eg those based on SV 40 or CMV. • Optimal conditions are as follows: Plasmid DNA should be circular DNA is mixed with Ca. Cl 2 in the presence of buffered saline medium at p. H 6. 95 in the presence of the cells During the following hours (usually overnight) a calcium phosphate DNA complex is formed which slowly precipitates on the cell surface p. H is critical, as is CO 2 concentration – 2 -4%- (less than in cell cultures. . 5 -10%) • Other methods include electroporation and lipofection (DNA • After DNA treatment cells can be left to express introduced DNA packaged into cationic lipids). without selection OR subject to selection, eg with G 418 (using npt. II/neo gene). See Chen and Cohen (1987)
Mammalian Cell Transformation • Calcium phosphate co-precipitation techniques • Both transient expression and stable transformation can be achieved at high frequencies of standard cells lines such He. La, CHO, NIH 3 T 3. 10 -50% of all cells • Procedure is often termed tranfection • Shuttle vectors used, eg those based on SV 40 or CMV. • Optimal conditions are as follows: Plasmid DNA should be circular DNA is mixed with Ca. Cl 2 in the presence of buffered saline medium at p. H 6. 95 in the presence of the cells During the following hours (usually overnight) a calcium phosphate DNA complex is formed which slowly precipitates on the cell surface p. H is critical, as is CO 2 concentration – 2 -4%- (less than in cell cultures. . 5 -10%) • Other methods include electroporation and lipofection (DNA • After DNA treatment cells can be left to express introduced DNA packaged into cationic lipids). without selection OR subject to selection, eg with G 418 (using npt. II/neo gene). See Chen and Cohen (1987)
 Mammalian Cell Transformation cont. Mouse transformation Method 1: Transformation of fertilized egg by microinjection gives rise to transgenic animal • Linear DNA is used, integrated at random, multiple copies Method 2: Transformation of embryonic stem (ES) cells • More complex procedure • ES cells transformed with DNA capable integration by homologous recombination Linearised insert from plasmid Mouse DNA Transgene or deletion Homologous target sequences of mouse genome • Mice produced are chimeras (mix of transformed and untransformed tissue). % will produce totally transformed offspring.
Mammalian Cell Transformation cont. Mouse transformation Method 1: Transformation of fertilized egg by microinjection gives rise to transgenic animal • Linear DNA is used, integrated at random, multiple copies Method 2: Transformation of embryonic stem (ES) cells • More complex procedure • ES cells transformed with DNA capable integration by homologous recombination Linearised insert from plasmid Mouse DNA Transgene or deletion Homologous target sequences of mouse genome • Mice produced are chimeras (mix of transformed and untransformed tissue). % will produce totally transformed offspring.
 Microinjection of embryo
Microinjection of embryo
 Transformation of embryonic stem (ES) cells
Transformation of embryonic stem (ES) cells
 Transformation of plants • Requirements – Ability to regenerate whole fertile plants from single transformed cells (totipotency) • Requires tissue culture and regeneration method (hormone regime) – DNA construct containing: • Gene of interest • Selectable marker gene – Transformation method – Selection system (usually antibiotic or herbicide) • Two most common transformation methods: – Agrobacterium-mediated – Direct gene transfer (DGT): Biolistics
Transformation of plants • Requirements – Ability to regenerate whole fertile plants from single transformed cells (totipotency) • Requires tissue culture and regeneration method (hormone regime) – DNA construct containing: • Gene of interest • Selectable marker gene – Transformation method – Selection system (usually antibiotic or herbicide) • Two most common transformation methods: – Agrobacterium-mediated – Direct gene transfer (DGT): Biolistics
 Tissue culture and regeneration of plants Can be done from a wide range of plant parts, and is determined empirically. Such parts are called explants Leaf discs (eg. tobacco) Tuber discs (eg. potato) Scutellar tissue (eg. rice, cereals) Cotyledons (tomato) • Regeneration to whole plants usually achived on Seedling stems (brassicas) nutrient medium containing phytohormones (combination of auxins and cytokinins) • Two types of regeneration: 1. Organogenesis. Shoot forms, then detached and rooted (tobacco) 2. Embryogenesis. Embryo forms which then “germinates” (cereals)
Tissue culture and regeneration of plants Can be done from a wide range of plant parts, and is determined empirically. Such parts are called explants Leaf discs (eg. tobacco) Tuber discs (eg. potato) Scutellar tissue (eg. rice, cereals) Cotyledons (tomato) • Regeneration to whole plants usually achived on Seedling stems (brassicas) nutrient medium containing phytohormones (combination of auxins and cytokinins) • Two types of regeneration: 1. Organogenesis. Shoot forms, then detached and rooted (tobacco) 2. Embryogenesis. Embryo forms which then “germinates” (cereals)
 Tobacco leaf discs, regenerating shoots
Tobacco leaf discs, regenerating shoots
 Tobacco transformation (continued) 3 months Rooting step
Tobacco transformation (continued) 3 months Rooting step
 Rice transformation
Rice transformation
 Agrobacterium-based Transformation • Agrobacterium tumefaciens: Nature’s genetic engineer • Soil-borne plant pathogen: crown gall tumours • Can transfer some of its own DNA (found on the Ti plasmid) into plant chromosomes • Plant cells then make nutrients for bacterial cells to use • T-DNA: ‘left’ and ‘right’ border signals; between these are the oncogenic (tumour formation) and opine (nutrient) genes
Agrobacterium-based Transformation • Agrobacterium tumefaciens: Nature’s genetic engineer • Soil-borne plant pathogen: crown gall tumours • Can transfer some of its own DNA (found on the Ti plasmid) into plant chromosomes • Plant cells then make nutrients for bacterial cells to use • T-DNA: ‘left’ and ‘right’ border signals; between these are the oncogenic (tumour formation) and opine (nutrient) genes
 Plant Tumours (Hyperplasias) induced by Agrobacterium
Plant Tumours (Hyperplasias) induced by Agrobacterium
 Typical Ti plasmid and its T-DNA Octopine type Codes for all the genes needed to transfer T-DNA from bacterium to plant cell nucleus • Modern binary vectors only have right and left T-DNA borders • Virulence genes for transfer can be supplied on separate plasmid
Typical Ti plasmid and its T-DNA Octopine type Codes for all the genes needed to transfer T-DNA from bacterium to plant cell nucleus • Modern binary vectors only have right and left T-DNA borders • Virulence genes for transfer can be supplied on separate plasmid
 • • Ti plasmids (continued) Ti plasmid ‘disarmed’: oncogenic and opine genes removed Gene of interest (plus antibiotic resistance gene) inserted between T-DNA borders Plasmid transferred into Agrobacterium transforms plant cells Transformed cells selected (antibiotic) Transgenic plants regenerated Advantages – low copy number – genes integrated into active regions in chromosomes • Disadvantage: limited by host range
• • Ti plasmids (continued) Ti plasmid ‘disarmed’: oncogenic and opine genes removed Gene of interest (plus antibiotic resistance gene) inserted between T-DNA borders Plasmid transferred into Agrobacterium transforms plant cells Transformed cells selected (antibiotic) Transgenic plants regenerated Advantages – low copy number – genes integrated into active regions in chromosomes • Disadvantage: limited by host range
 Transformation of plant cells by Agrobacterium
Transformation of plant cells by Agrobacterium
 Direct Gene Transfer Biolistics • DGT – any method using naked DNA delivery to plant cells • Biolostics most successful technology • Also known as microprojectile bombardment • DNA precipitated onto microscopic gold or tungsten particles • Particles accelerated into plant cells using a ‘gene gun’ • Transgenic cells selected, whole plants regenerated • Advantage over Agrobacterium: not limited by host range • Disadvantage: higher copy number
Direct Gene Transfer Biolistics • DGT – any method using naked DNA delivery to plant cells • Biolostics most successful technology • Also known as microprojectile bombardment • DNA precipitated onto microscopic gold or tungsten particles • Particles accelerated into plant cells using a ‘gene gun’ • Transgenic cells selected, whole plants regenerated • Advantage over Agrobacterium: not limited by host range • Disadvantage: higher copy number
 Biolistics - process + Gold (1 µm) Selection, regeneration
Biolistics - process + Gold (1 µm) Selection, regeneration


